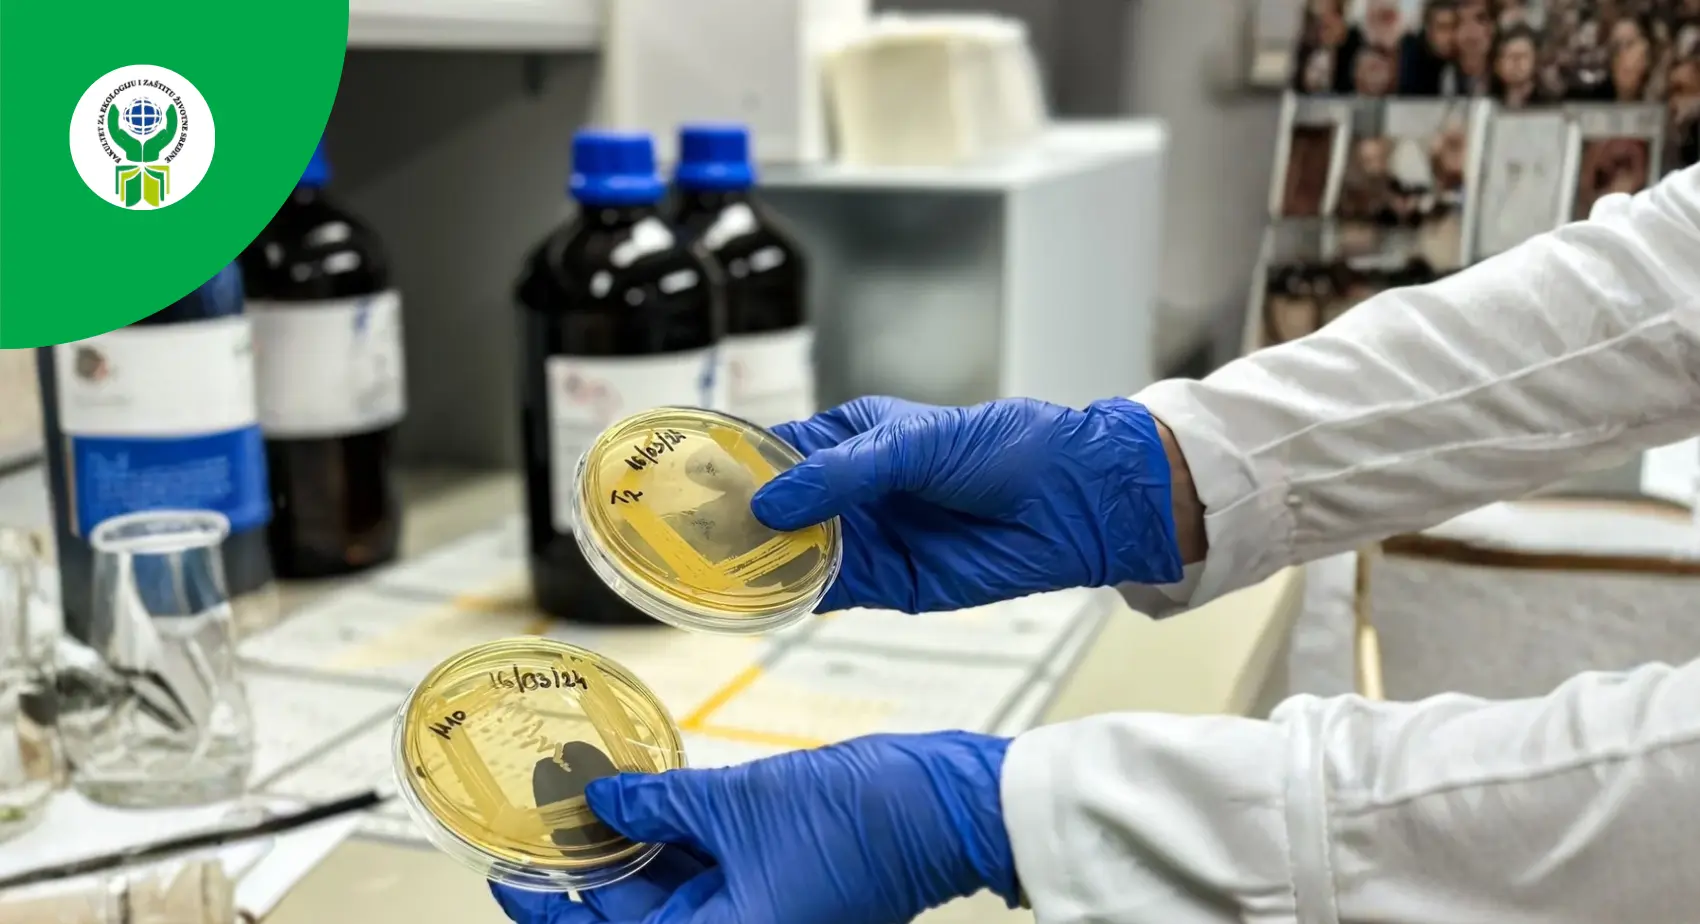

Environmental Protection
Environmental Protection
Short Description
The structure of the study program provides academic-general education courses (12,08%), theoretical-methodological courses (22,50%), scientific-professional courses (32,71%) and professional-applied courses (32,71%). It is also fulfilled that elective subjects are represented by 20,42% ESPB points.
The total number of one-semester courses is 36, of which 30 are compulsory and 6 are optional one-semester courses (chosen from 12 proposed courses). In addition to compulsory and optional subjects, in the fourth year professional practice, research contained in the final paper - IR and preparation and defense of the final paper are foreseen.
The first three years represent the basic, general and joint education of all students of this educational program. In the fourth year, students specify the problems in compulsory and optional subjects. Through elective courses, students satisfy their individual affinities, which developed during the first three years of study.
All courses are one-semester and carry the appropriate number of ECTS points, where one point corresponds to approximately 30 hours of student activity. The sequence of subjects in the study program is such that the knowledge needed for subsequent subjects is acquired in the previously performed subjects.
The syllabuses (course specifications) define the description of each course, which includes the name, type of course, year and semester of study, number of ECTS points, teacher's name, course objective with expected outcomes, knowledge and competences, prerequisites for attending the course, course content, recommended literature , teaching methods, methods of checking knowledge and evaluation and other data. The study program is harmonized with European standards in terms of enrollment conditions, duration of studies, conditions for transferring to the next year, obtaining a diploma and methods of studying.
An integral part of the curriculum OAS Environmental Protection is professional practice, which is realized in public institutions or economic organizations.
The student completes his studies by writing a final paper, which consists of the theoretical and methodological preparation necessary for a detailed understanding of the area from which the final paper is written, and the preparation of the paper itself. The final paper consists of the creation and defense of the work and is defended before a committee consisting of at least 3 teachers. The content of the study program provides the necessary knowledge for the employment of graduated students or for further training in master's studies.
The purpose of the study program
The purpose of the OAS-Environmental Protection study program is to educate profile staff - graduate environmental protection analysts. The structure of the study program ensures that academic education in the field of environmental protection is continuously improved through the teaching content of compulsory and optional subjects. The study program enables the application of knowledge and skills and training for professional work in economic activities. Acquired competences and skills, at this level of study, represent a body of fundamental knowledge for continuing education at master's studies in environmental protection and related profiles.
Specific purpose of the study program OAS - Environmental protection is the provision of a life protection analyst who possesses the competencies, knowledge and skills that, above all, relate to the prevention, control and remediation of air, water and soil pollution, waste management, rational use of natural resources, use of renewable energy sources, as well as the ability to participate in writing various studies related to the state of the environment.
Objectives of the study program
The goals of the study program are to educate Graduated environmental protection analysts which one:
- possess sufficient theoretical knowledge from the basic theoretical disciplines and natural sciences (mathematics, physics, chemistry, biology/ecology, mechanics, thermodynamics) and are able to apply them in order to create a clear picture of the processes taking place in industrial systems and the environment,
- possess sufficient professional knowledge and skills, with the application of which they can monitor the state of quality of all environmental media, understand the causes of their pollution, influence the prevention and reduction of pollution of the living and working environment, operationally manage and control systems for the preparation of water for many purposes, purification of waste water and gases, remediation and recultivation of polluted land, treatment and final disposal of solid and hazardous municipal and industrial waste, define measures and evaluate effects for increasing energy efficiency and the use of renewable energy sources,
- accept scientific methodology in the context of needs and activities: a) understand the role of formal models and results of natural sciences in understanding and designing technical systems, b) are able to apply known methods and techniques, c) are able to evaluate arguments, assumptions, concepts and data , in order to correctly judge and contribute to solving complex problems,
- are trained to work in a team, in the context of larger projects,
- are able to present information, ideas, problems and solutions both to experts in the subject area and to those who do not have specialties related to the area of presentation,
- are aware of how their profession can influence in the context of ethical, aesthetic, social, economic and safety issues,
- are qualified for further learning with the aim of training in an academic and/or professional sense,
- they understand the limited scope of acquired knowledge and have a need for further and permanent training, they are able to communicate with local and foreign experts from their own and other fields, using professional terminology.
The main goal of the study program
The main goal of the study program OAS Environmental Protection of basic academic studies at the University "Union - Nikola Tesla", Faculty of Ecology and Environmental Protection, is the education of personnel with a high degree of expertise to perform complex and creative jobs in the field of environmental protection from the natural-mathematical field and the scientific field - environmental science, with the aim of obtaining an academic title - Graduated environmental protection analyst.
Graduated environmental protection analyst is trained to recognize, formulate and analyze problems independently and to offer one or more acceptable solutions, which implies:
- to have a developed analytical and creative approach to solving theoretical and practical problems,
- to be able to integrate information and numerical data from different sources and connect them in order to solve a specific task,
- to demonstrate commitment and ability in the performance of experimental and other project tasks, as well as in the analysis of conclusions and presentation of reports, that he is capable of reasonable analytical and managerial reasoning.
Outcomes of the study program
The student is qualified for independent or team work in all types of organizations on issues of environmental protection analysis.
You can view the certificate of accreditation of the study program from 2023 HERE.
You can view the plan and program of bachelor academic studies by accreditation from 2023 HERE.
You can view the certificate and decision on accreditation of the study program from 2016 HERE.
You can view the plan and program of bachelor academic studies according to accreditation from 2016 HERE.
You can download the course book in RAR file format HERE
